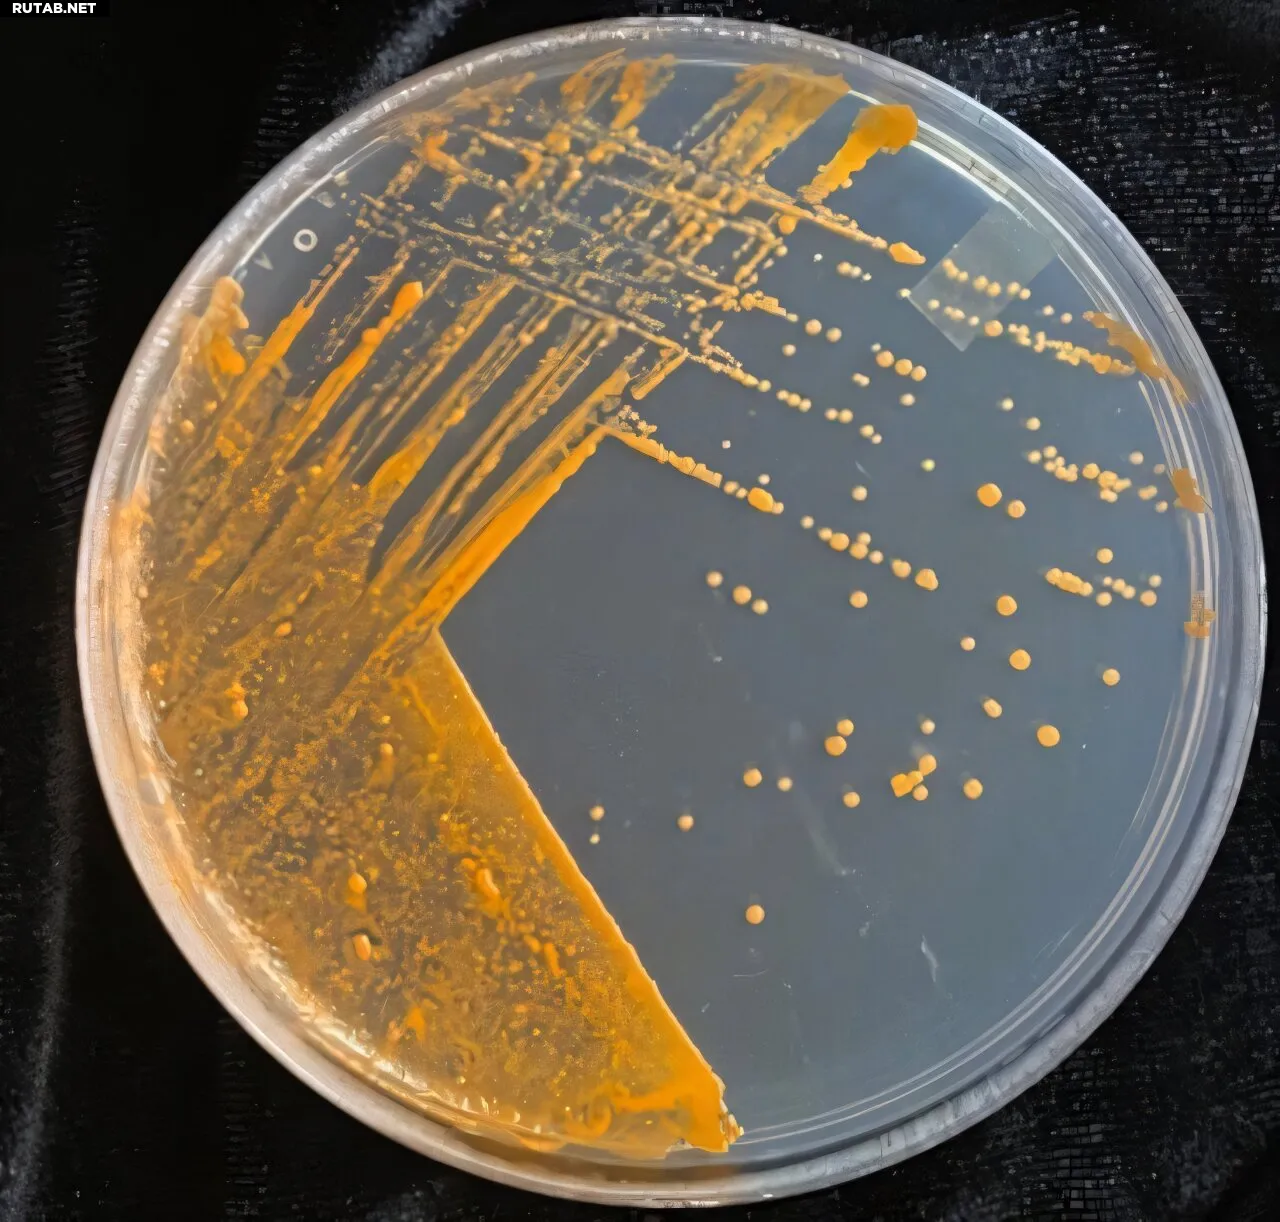

Бактерии помогут спасти вино от дымного привкуса после лесных пожаров
Штамм Gordonia alkanivorans Vvg01, способный разлагать гваякол как единственный источник углерода, растущий на минимальной среде. Автор: Клаудия Кастро, CC-BY 4.0 (https://creativecommons.org/licenses/by/4.0/)
Новые лабораторные эксперименты показывают, что бактерия, обитающая на виноградных растениях, может расщеплять гваякол — вещество с неприятным вкусом, которое портит вино, произведённое из винограда, подвергшегося воздействию дыма лесных пожаров. Клаудия Кастро из Службы сельскохозяйственных исследований Министерства сельского хозяйства США и её коллеги представили эти находки в журнале PLOS One.
Лесные пожары всё чаще случаются в винодельческих регионах западного побережья США. Виноград может поглощать вещества из дыма лесных пожаров, которые в конечном итоге попадают в бутылку, придавая вину дымный, пепельный привкус. Предыдущие исследования показали, что одно из таких веществ, гваякол, может расщепляться определёнными видами бактерий, живущих в почве, что открывает возможность использования бактериальных метаболических процессов для улучшения вкуса «задымлённого» вина.
Однако лишь немногие исследования изучали, обладают ли способностью разлагать гваякол бактерии, естественным образом обитающие на виноградных лозах как часть микробиома растений. Чтобы исследовать эту возможность, Кастро и её коллеги собрали листья с двух сортов виноградных растений — шардоне и каберне совиньон — и проверили их в лаборатории на наличие поедающих гваякол бактерий.
Они обнаружили, что на листьях присутствуют два штамма одного и того же вида бактерий, Gordonia alkanivorans, которые способны расщеплять гваякол в лабораторных условиях. Анализ их геномов выявил конкретные гены, участвующие в этом метаболическом процессе, включая ген под названием guaA. Когда этот ген экспериментально удалили в клетках G. alkanivorans, бактерия потеряла способность расщеплять гваякол, что подтвердило необходимость гена guaA для деградации гваякола.
Исследователи также подвергли живые растения мерло воздействию дыма от кулинарной коптильни — имитируя воздействие дыма лесного пожара — и проверили, какие виды бактерий присутствовали на растениях до и после. Они обнаружили, что микробиом как на листьях, так и на ягодах (винограде) значительно изменился в течение дней после воздействия дыма, с заметным увеличением количества бактерий класса Bacilli, которые известны своей способностью выживать в экстремальных условиях.
В последние годы «задымлённое» вино стоило участникам индустрии миллионы долларов. Эти новые открытия могут помочь проложить путь к разработке биотехнологических стратегий, которые превратят естественное бактериальное разложение неприятных на вкус веществ в инструменты для спасения вкуса.
Кастро добавляет: «В этом исследовании мы идентифицировали два представителя микробиома винограда, способные разлагать гваякол, летучий фенол, который способствует «дымному» дефекту вина. Мы также выявили изменения в микробиоме винограда, вызванные имитацией дыма лесного пожара, с целью предоставления генетических инструментов для борьбы с дымным привкусом».
«Работа на винограднике вместе с нашим сотрудником доктором Томом Коллинзом и его командой по настройке симуляции дыма лесного пожара — одно из моих лучших воспоминаний об этом исследовании. Вероятно, второе по значимости после обнаружения микроба, разлагающего гваякол, который живёт на поверхности винограда».

0 комментариев